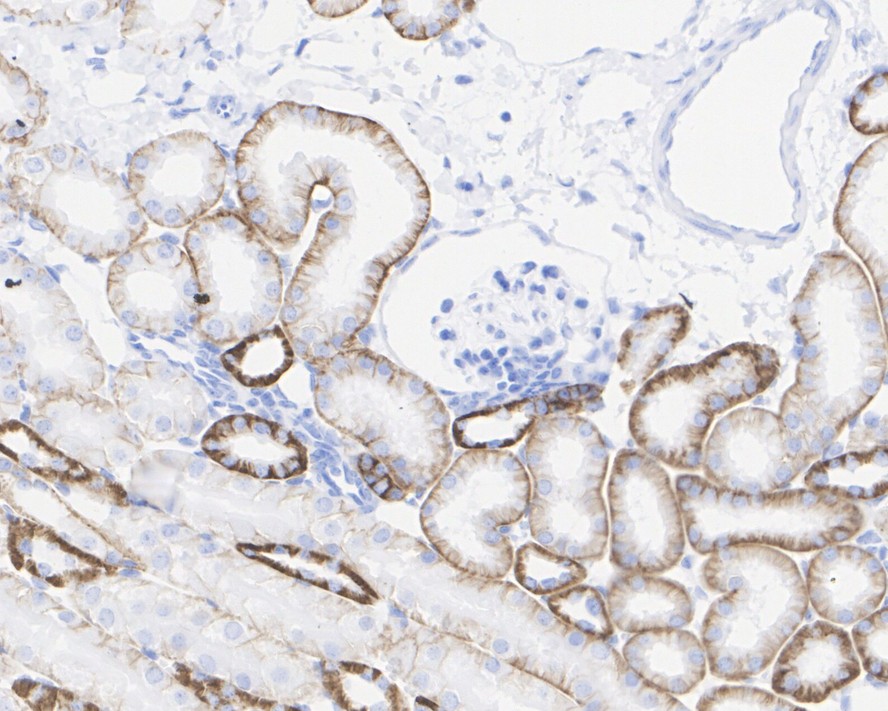

Catalog# HA722408
Cadherin 16 Recombinant Rabbit Monoclonal Antibody [JE60-37]
Application
-
WB
-
IHC-P
-
IF-Tissue
Reactivity
-
Human
-
Mouse